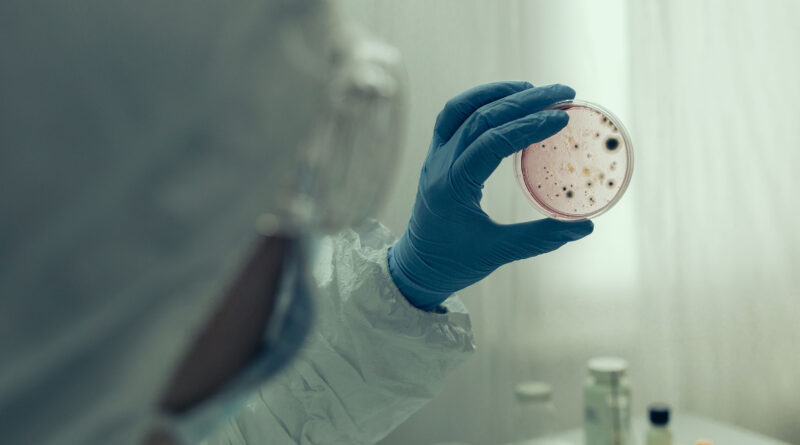

Infectologista da Unimed JP orienta reforçar protocolos de saúde para prevenir covid-19 e gripe
Em meio a um aumento dos casos de covid-19 — principalmente devido à variante ômicron — e gripe, causada pela Influenza A (H2N3), seguir à risca os protocolos de saúde é ainda mais importante. Medidas simples e eficazes como usar máscara corretamente, higienizar as mãos e evitar aglomerações são fundamentais para prevenir novos casos.
Segundo o médico infectologista cooperado do plano de saúde Unimed João Pessoa, Francisco de Assis, o aumento de casos de covid-19 e gripe têm duas razões distintas. “Temos a circulação de uma nova variante, a ômicron, que é mais contagiosa, tem um poder maior de transmissibilidade. Já em relação à influenza houve uma situação atípica com a circulação da H3N2 no mesmo período. Esse tipo de vírus ainda não está contemplado na vacinação feita anualmente, então, não temos imunidade ou temos de forma parcial. A vacina contra H3N2 deve ser aplicada quando iniciar a campanha em abril ou maio”, explica.
Para a prevenção, o médico orienta seguir o protocolo de segurança, que é o mesmo para as duas situações: higienização das mãos, uso de máscaras e evitar locais com aglomeração. “Essas medidas devem ser mantidas independentemente da situação vacinal, porque não sabemos ainda quanto tempo dura a nossa imunidade”, lembra Francisco de Assis.
Vacinação — Segundo o infectologista, a imunização mudou drasticamente o perfil dos pacientes que são atendidos em hospitais. O infectologista lembra que antes havia um grande número de casos graves e que isso causou um forte impacto nos serviços hospitalares e também na mortalidade. “Hoje, felizmente, uma considerável parcela da população está vacinada e a maioria dos casos é leve, com pouco impacto na internação hospitalar. É importante que todos se vacinem, assim haverá a imunidade coletiva e não terá espaço para um vírus ser transmitido de uma pessoa para outra. Assim, caem as chances de surgimento de novas variantes com pouca sensibilidade à vacina”, destaca.
Em relação às crianças, os protocolos de segurança também devem ser mantidos mesmo com o avanço da vacinação neste público. De acordo com Francisco de Assis, a imunidade não surge após a primeira dose, serão duas, e a imunização total só ocorre após duas semanas da segunda aplicação. “Mesmo com a vacinação já iniciada é importante que se mantenham as medidas de segurança, pois elas servem não apenas contra a covid, mas também outras viroses respiratórias, como a influenza”, arremata.
Veja medidas de segurança contra infecções respiratórias:
- Usar máscara (a mais segura possível, de preferência N95 ou PFF2);
- Higienizar as mãos com água e sabão ou álcool a 70% com frequência;
- Evitar tocar olhos, nariz e boca com as mãos não lavadas. Se tocar, sempre higienize as mãos como já indicado;
- Evitar aglomerações, principalmente em espaços fechados e manter os ambientes limpos e bem ventilados;
- Manter uma distância mínima de cerca de 1 metro de qualquer pessoa tossindo ou espirrando;
- Evitar abraços, beijos e apertos de mãos. Adote um comportamento amigável sem contato físico; e
- Higienizar com frequência os brinquedos das crianças e aparelho celular. Não compartilhar objetos de uso pessoal, como talheres, toalhas, pratos e copos.
Sobre a Unimed JP – A Unimed João Pessoa é uma cooperativa de trabalhos médicos que se consolidou como a melhor e maior operadora de planos de saúde da Paraíba. Além dos mais de 1,8 mil médicos cooperados, possui a mais completa rede de assistência médico-hospitalar privada do Estado. São diversos hospitais credenciados, sendo dois próprios – um deles referência em alta complexidade -, além de clínicas, prontos-socorros e laboratórios à disposição de 155 mil clientes. Comprometida com o desenvolvimento sustentável, é signatária do Pacto Global da Organização das Nações Unidas (ONU). Tudo isso garante à Unimed JP a liderança absoluta no segmento de saúde suplementar no mercado paraibano.
Fonte: Paraíba.Com